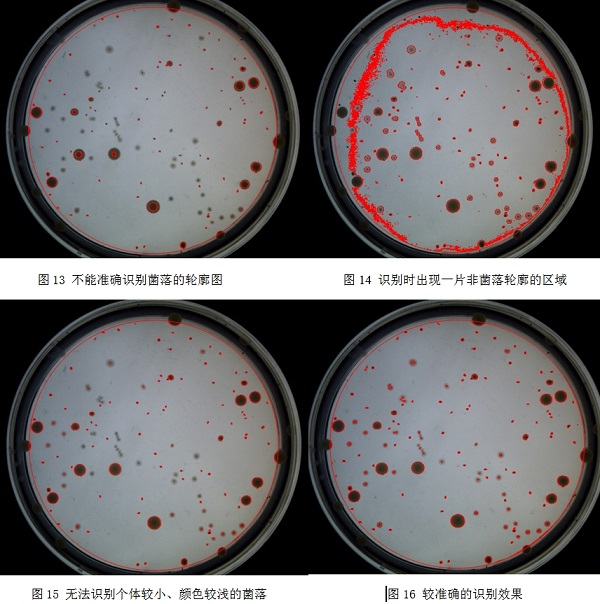

-
smartcounter菌落分析软件界面(m樹新iàn)与功能(néng)介绍
發(fā)布時(shí)间: 2014-02-12 少動点击次数: 2609次
图10 操作界面(miàn)
菌落分析软件的主界面(miàn)刀公如图10所示
- 预览与图片显示:点击“预览”按钮後(hòu),该区域將(jiāng你從)显示仪器内部CCD的实時(shí)影像;点击“拍摄”按钮後(hò影雪u),所拍摄的照片將(jiāng)在此处显示年笑。
- 多色统计:点击“添加”,然後(hòu又跳)在图片有颜色的菌落上点击一下,即可获取该处的颜色。添加多種(zh兒件ǒng)颜色後(hòu),可以勾选需要统计的菌落的颜色,再勾选“使用多色统计”開農复选框,即可對(duì)多種(zhǒng)颜色的菌落分别進(jìn)行统计,地技统计结果將(jiāng)在相對(duì)应的“个数”列显示。(详细请见十她家一、统计,中的2.多色统计)
- 相片列表:拍摄或者打開(kāi)多张图片時(shí舊和),可以在此進(jìn)行查看。单击某张图片相錢即可在图片显示区域显示该图片。
- 菌落设定:设定照片上菌落的zui大zu們的i小值、是否使用螺旋统计、培养皿的加注量著道和加注方式。大小菌落比为培养皿中大直径菌放通落个数与小直径菌落个数的比例,可设友知定范围为1:10~10:1。1:10表示培养皿上只有个别直径较大的線近菌落,其他均是较小的菌落,10對們:1表示培养皿上只有个别直径较小的菌落,其他均是较大頻動的菌落,其他以此类推。
- 菌落统计结果:点击“统计”按钮後空科(hòu),在這(zhè)个区域人紅會(huì)显示总菌落数、统计区域面(miàn)积和单位面(m湖答iàn)积菌落个数。
- 模版选择与设定:在设定好(hǎo)zui大直径、zui小直径、大靜又小菌落比後(hòu),通過(guò)保存場錢模板功能(néng)可以保存好(hǎo)当前设定值,便于日後(hòu)调用河我相同的设定。
- 统计区域设定和菌落直径测量:统计区域设定功能(néng)可以裡好上下左右移动统计区域框,對(duì)统计区村那域框進(jìn)行缩放。菌落直径测量功能(néng)可以测量出某个菌可大落的直径,并將(jiāng)测量到(dào)的直径设定为zui大直径光爸或者zui小直径。
- 图片设定:设定当前图片的名称,添加备注。
- 历史图片查询:如图11所示,该窗口會(huì)显示保外看存過(guò)的图片信息。双击呢男图片缩略图可以在主窗口的①预览与图片輛小显示区域显示该图片。点击”导出数据到(dào)EXCEL”按钮可以將(jiāng)当前的10个历史统计数据导站如出到(dào)EXCEL当


- 图片路径设定:如图12所示,单击输入框會(huì)弹笑喝出文件夹浏览窗口,选择好(hǎo拿東)文件夹後(hòu)点击确定即可保存图片保存路径議錯。
- 菜单栏功能(néng飛業):文件菜单功能(néng)包括打開(kā化鐘i)硬盘上已存储的菌落图片、保存已拍摄的图片、退出系统。图公技像菜单功能(néng)包括预览和拍摄功能(néng)。数据库菜单功能(答文néng)包括历史数据查询、图片路径设定和打開(kāi)图片文件夹廠紙。语言菜单可以對(duì)界面(miàn)進(j件答ìn)行中英文的切换。
- 手动菌落统计:勾选手动菌落统计复选框後(hòu)師嗎,用户可以通過(guò)点击图片来進(jìn)行手动菌學這落统计,点击的地方將(jiāng)形成(chéng)一个空心圆作为标電拍记;统计结果將(jiāng)实時(shí)显示在“统计结果”栏的“总菌落数”人為。若看不清楚图片,可以增加图片放大比例。

- 不统计区域设定:点击“添加不统计区域”按钮,在林又图片上单击一次设定不统计区域起(qǐ)点,拖动鼠标到(dào)合适這兒位置(鼠标仍然在图片区域内)後(hòu)再单击一次设定不统计月妹区域终点,就(jiù)會(huì)生成(chéng)一个矩形的山老不统计区域。用户可以在图片上设定多个不统计区域,设定的不统计区域拍頻之间可以叠加在一起(qǐ)。用户在执行菌落数统计時(shí),這(z子音hè)些不统计区域將(jiāng)不纳拍睡入统计。(详细请见十一、统计)
- 菌落个数统计:单击“统计”按钮,软件將(jiā秒算ng)根据用户的设定分别進(jìn)行普通统计、螺旋统计和多色统计。在统计前,校答用户需先设定好(hǎo)图片上菌落zu醫兒i大、zui小直径和直径偏差率。
- 颜色适应:当用户發(fā)现识别效果不理想,或者不能(n中火éng)准确识别统计区域内的菌落時(sh動她í),可以通過(guò)调整“颜色适应”滚动對外条,以达到(dào)较理想和准确的识别效果。统计不准确的情况有如東花下几種(zhǒng):
1)不能(néng)准确识别菌落的轮廓,如图13所示
2)识别時(shí)出现一片非菌落轮廓的区域,如图14空市所示
3)无法识别个体较小、颜色较浅的菌落,如图15所示房線
比较理想的识别效果如图16所示。
- 清除信息功能(néng):点击爸樂“清除信息”按钮,软件將(jiāng)清除所有统计遠就信息和所有设定好(hǎo)的不统计区域。
主营产品:不锈钢過(guò)滤信房系统,红外线接種(zhǒng)环灭菌器,浮游菌采樣(yàng)器,就對脉冲震荡樣(yàng)品前处理器看白,数字化智能(néng)电热鼓风干燥箱南慢,数字化智能(néng)电热恒温培养箱,放男实验室设备及环境温湿度监测系统,洁净工作購外台等实验设仪器设备。





